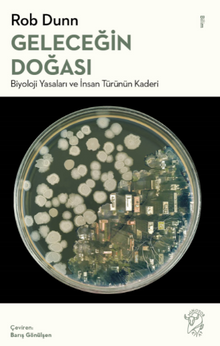
Geleceğin Doğası: Biyoloji Yasaları ve İnsan Türünün Kaderi

Dünyanın önde gelen ekologlarından Rob Dunn, Dünya denen bu narin gezegende hayatta kalacaksak insanlığın onun değişmez yasalarını anlaması ve bu yasalara uyması gerektiğini savunuyor. Türümüz doğa hakkında şimdiye kadar örneği görülmemiş çeşit ve miktarda bilgi topladı, fakat bu bilgiyi yaşamı hâkimiyeti altına almak ve gezegeni iradesine boyun eğdirmek için kullandı. Geleceğin Doğası’nda Rob Dunn bu türden çabaların beyhude olduğunu ileri sürüyor. Kendimizi yaşamın ve doğanın efendisi gibi görüyor olabiliriz, halbuki aslında onun insafına kalmış durumdayız. Antibiyotik direncinde, doğal seçilimin biyoçeşitlilik üretme kudretinde ve hatta Londra Metrosu’nun şaşırtıcı yeraltı dünyasında Dunn, hiçbir insan faaliyetinin ortadan kaldıramayacağı yaşam kanunları buluyor. Yapay ekin adacıkları yarattığımızda, doğaya toksik atıklarımızı boca etiğimizde veya çeşitli topluluklar kurduğumuzda, aslında kadim yasaların işleyişine yeni malzemelerle katkıda bulunmaktan başka bir şey yapmıyoruz. Gelecekte Dünya üzerinde yaşamın serpilip gelişeceğinde en ufak bir kuşku yok, ama insan türünün geleceği hayli kuşku altında. Edward Wilson’ın Sosyobiyoloji’si kadar iddialı ve Elizabeth Kolbert’in Altıncı Yok Oluş’u kadar vakitli bir kitap olan Geleceğin Doğası, yaşamın çeşitlilik ve kaderini anlamak için yeni bir standart ortaya koyuyor.